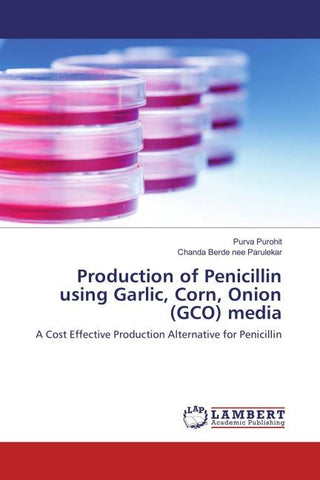
Production of Penicillin using Garlic, Corn, Onion (GCO) media

Autorenfreundlich Bücher kaufen?!

Beschreibung
The present study was aimed at finding the potential of vegetable waste as a production media for fungal cultures.Recent research has been focused on finding alternatives to gelling agents of media, agar in particular, and media, in general, because of its exorbitant price. The agricultural waste contains vast amounts of nutrients, which can be harnessed growth of microorganisms and subsequent production of useful primary and secondary products like enzymes, organic acids like lactic acid, citric acid etc. This project focuses on formulation and standardization of a microbial medium from agricultural and market waste, that can be used commercially. Residues selected for this study are dried peels of onion, corn and garlic. This media was used for the growth of Penicillium chrysogenum, under submerged fermentation and the production of penicillin was monitored and optimised. The findings of the present study are quite encouraging as the growth, sporulation as well as the production of penicillin was better in the formulated media.
A Cost Effective Production Alternative for Penicillin
Details
| Verlag | LAP LAMBERT Academic Publishing |
| Ersterscheinung | 08. August 2016 |
| Maße | 22 cm x 15 cm x 0.6 cm |
| Gewicht | 131 Gramm |
| Format | Softcover |
| ISBN-13 | 9783659916397 |
| Seiten | 76 |